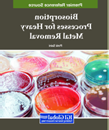

Akademická knižnica zakúpila e-knihy, ktoré sú prístupné cez IP rozhranie STU alebo VPN prístup. Prehľad zakúpených e-kníh:
![]() |
9781315163819 |
![]() |
9780429102660 |
![]() |
9780429234651 |
![]() |
9780080510064 |
![]() |
9780080460604 |
![]() |
9798369340547 2024 Municipal Solid Waste Management and Recycling Technologies Ritika Mehra, Pramendra Kumar, Bui Hung E-book |
![]() |
9798369316184 |
![]() |
9798369319666 |
![]() |
9798369355138 |
![]() |
9798369313060 |
![]() |
9781799896838 |
![]() |
9781668476895 |
![]() |
9781799848707 |
![]() |
9781003486657 |
![]() |
9798369305270 |
![]() |
9798369320778 |
![]() |
9781799857709 |
![]() |
978-1-7998-6508-7 |
![]() |
979-8-3693-1335-0 |
![]() |
978-1-7998-9574-9 |
![]() |
978-1-6684-9267-3 |
![]() |
978-1-7998-6721-0 |
![]() |
979-8-3693-0782-3 |
![]() |
978-1-6684-6932-3 |
![]() |
979-8-3693-0993-3 |
![]() |
978-1-6684-6295-9 |
![]() |
9781315181080 |
![]() |
9781003005155 2022 Akshay Kumar Advanced Ceramics for Energy and Environmental Applications E-book |
![]() |
9780429458347 2020 Mustapha Mouloua; Peter A. Hancock Human Performance in Automated and Autonomous Systems, Two-Volume Set E-book |
![]() |
9780367809041 2020 James Aweya Switch/Router Architectures Systems with Crossbar Switch Fabrics E-book |
![]() |
9780429448867 2020 Ahmed Abdelbary Extreme Tribology Fundamentals and Challenges E-book |
![]() |
9780429282829 2019 Adedeji B. Badiru Project Management Systems, Principles, and Applications E-book |
![]() |
9781315156507 2020 Yu. I. Aristov Nanocomposite Sorbents for Multiple Applications E-book |
![]() |
9781003120926 2021 Bhuvan Unhelkar; Tad Gonsalves Artificial Intelligence for Business Optimization Research and Applications E-book |
![]() |
9781003109723 2022 Mohamed Thariq Hameed Sultan; S. Arulvel; K. Jayakrishna Composite and Composite Coatings Mechanical and Tribology Aspects E-book |
![]() |
9781003124825 2021 A. Bahurudeen; P.V.P. Moorthi Testing of Construction Materials E-book |
![]() |
9780429265587 2020 Zainul Huda Metallurgy for Physicists and Engineers Fundamentals, Applications, and Calculations E-book |
![]() |
9781003143659 2021 Rihai Wu; Xun Yang; Xia Zhou; Yibo Wang Enterprise Wireless Local Area Network Architectures and Technologies E-book |
![]() |
9780429282843 2022 Jagdish Chandra Patni; Hitesh Kumar Sharma; Ravi Tomar; Avita Katal Database Management System An Evolutionary Approach E-book |
![]() |
9781003241416 2022 Yu-Jin Zhang A Selection of Image Processing Techniques From Fundamentals to Research Front E-book |
![]() |
9781003042822 2021 Titus De Silva Integrating Business Management Processes Volume 1: Management and Core Processes E-book |
![]() |
9781003089636 2022 Abhinav Goel; Anand Chauhan; A.K. Malik Applications of Advanced Optimization Techniques in Industrial Engineering E-book |
![]() |
9781003038443 2022 David O’Hare Introduction to Safety Science People, Organisations, and Systems E-book |
![]() |
9781003356714 2023 A. Sylvester Bolokang, Maria Ntsoaki Mathabathe Advanced Materials Processing and Manufacturing Research, Technology, and Applications |
![]() |
9780429242762 2019 Composite Materials Engineering Modeling and Technology E-book |
![]() |
9781003120261 2021 Nanotechnology Principles and Applications E-book |